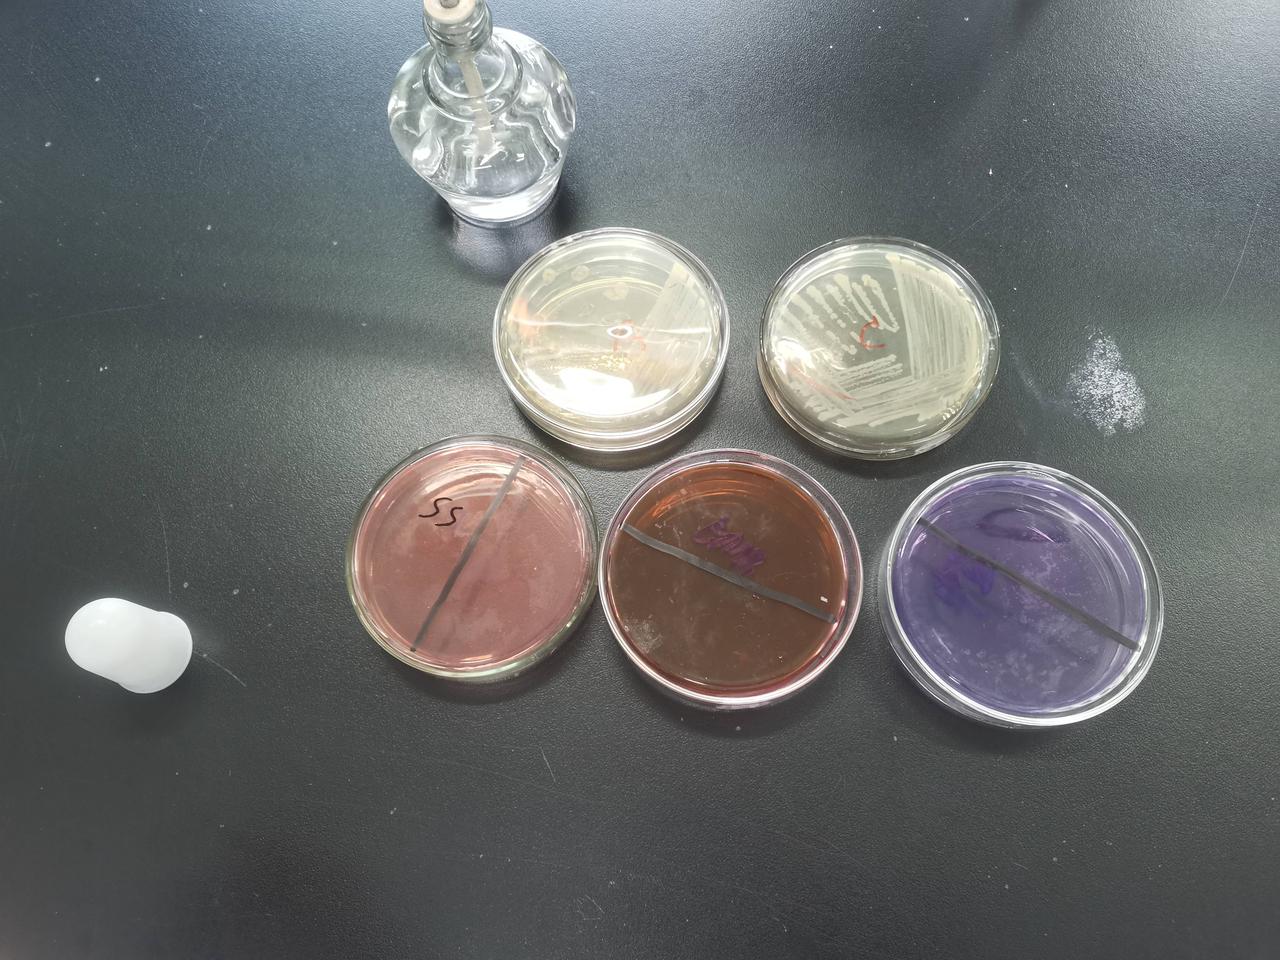
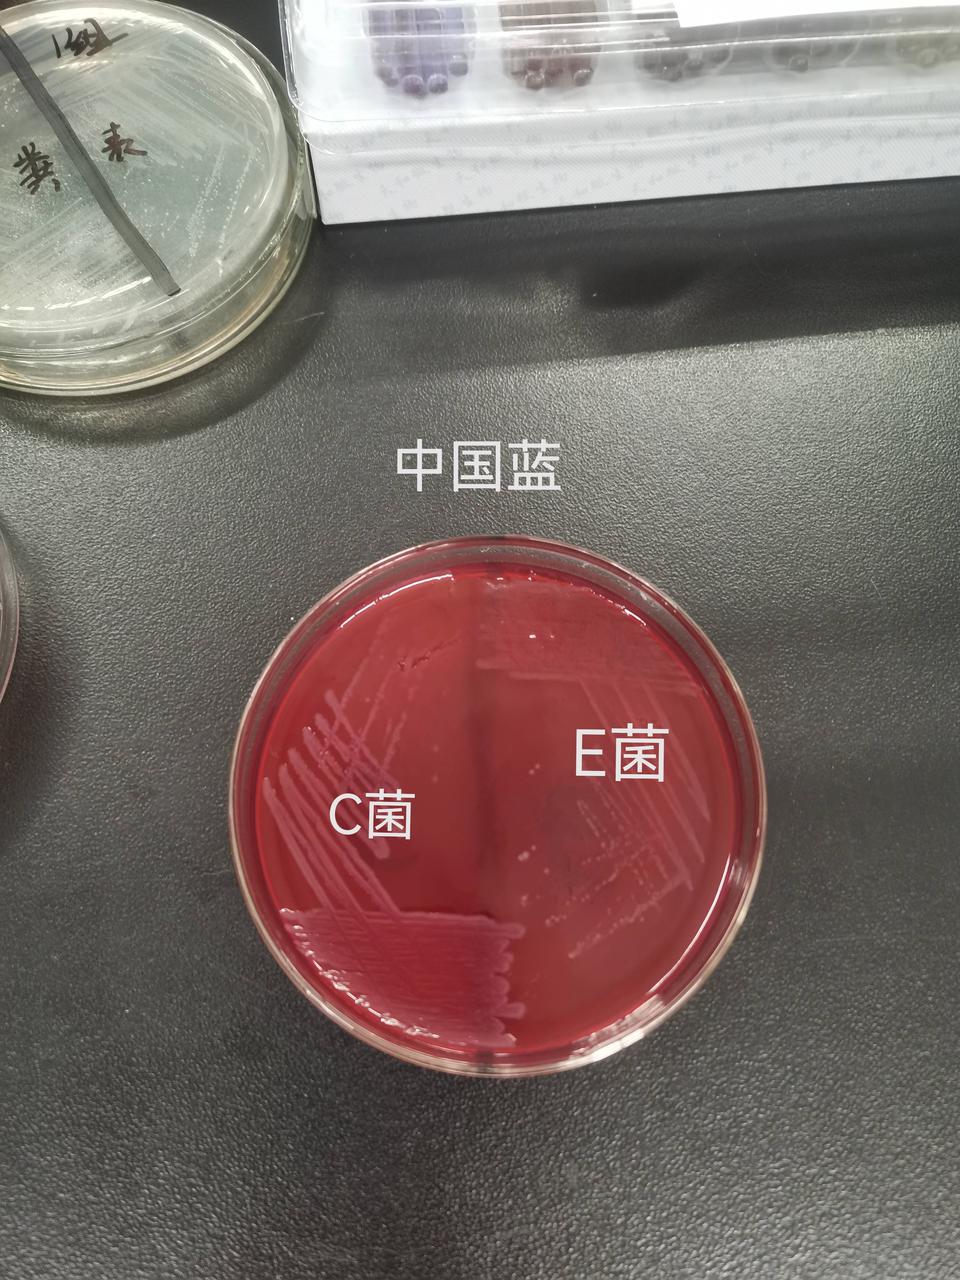
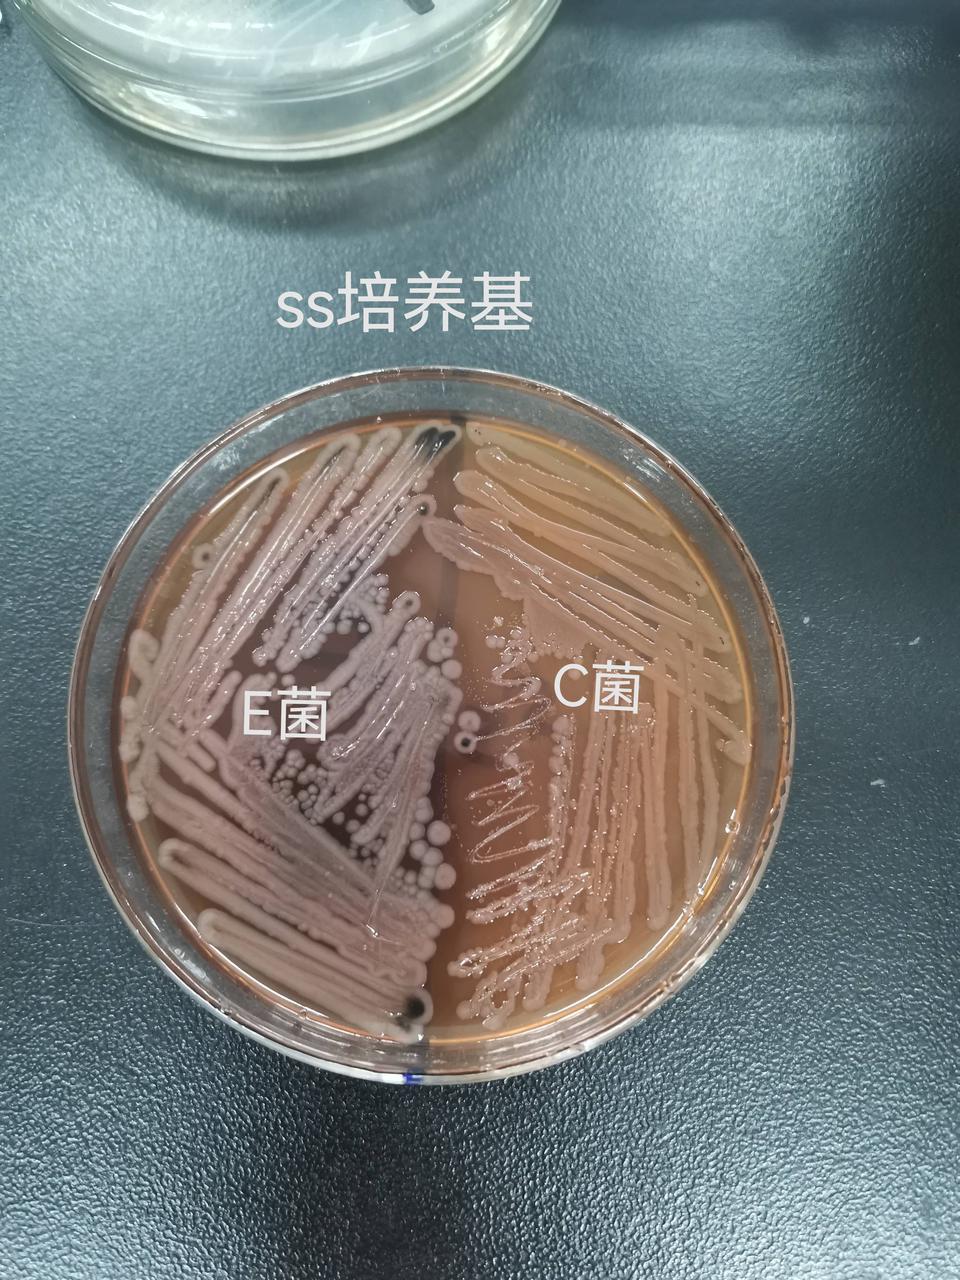
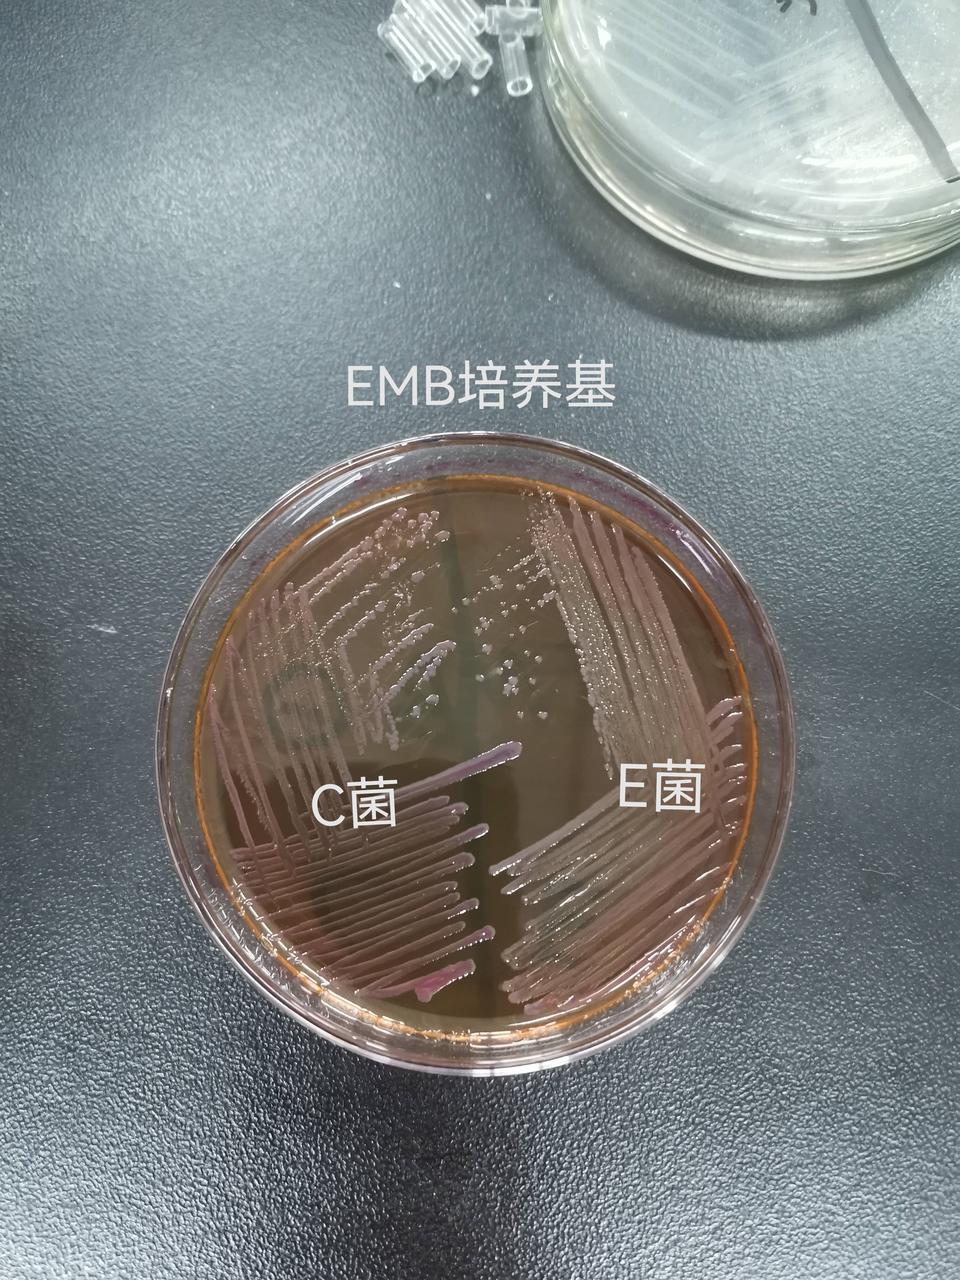

肠杆菌的鉴定
上一节
下一节
一、分离培养
从A B C D E5种肠杆菌种(大肠埃希菌,肺炎克雷伯菌,普通变形杆菌,伤寒沙门菌,志贺菌)任选2种进行接种,接种的肠道选择培养基如黑板所示:

选择CE两种菌,其分离培养结果如下图所示

二、革兰染色

三、生化鉴定
1.操作内容

2.生化结果

需要加试剂的后看结果的

生化反应管阴阳性结果变化参考

KIA接种后C菌结果
KIA接种后E菌结果

半固体培养C菌结果

半固体培养E菌结果


